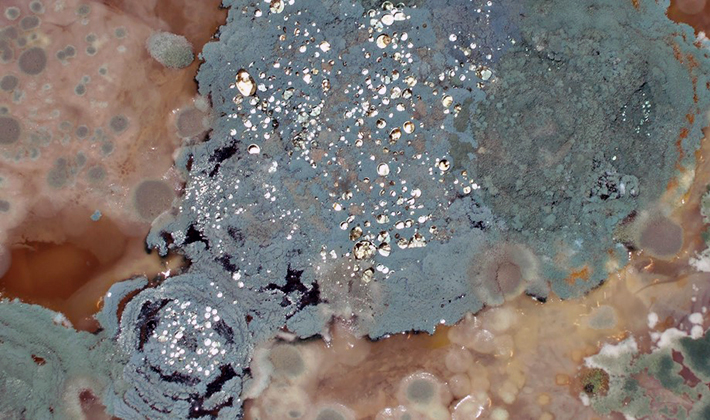

Types de moisissures lors de la culture des champignons
 La moisissure des champignons est la maladie la plus courante rencontrée par les producteurs de champignons lorsqu'ils élèvent des champignons et des pleurotes. Malheureusement, il n’existe aucun moyen efficace de lutter contre la moisissure des champignons frais et la protection des cultures consiste à mettre en œuvre en temps voulu des mesures préventives. Les principaux types de moisissures sont: vert, jaune, jaune-vert, confettis, carmin, toile d'araignée et olive. Ce qu'il faut faire pour prévenir la moisissure sur les champignons pendant la culture est décrit en détail sur cette page.
La moisissure des champignons est la maladie la plus courante rencontrée par les producteurs de champignons lorsqu'ils élèvent des champignons et des pleurotes. Malheureusement, il n’existe aucun moyen efficace de lutter contre la moisissure des champignons frais et la protection des cultures consiste à mettre en œuvre en temps voulu des mesures préventives. Les principaux types de moisissures sont: vert, jaune, jaune-vert, confettis, carmin, toile d'araignée et olive. Ce qu'il faut faire pour prévenir la moisissure sur les champignons pendant la culture est décrit en détail sur cette page.
Contenu
Pourquoi la moisissure verte apparaît-elle sur les champignons?

Moisissure verteEn règle générale, il affecte les champignons cultivés dans de grandes salles. La moisissure verte apparaît sur les champignons par différents types de squelettes, ils sont assez répandus dans la nature et apparaissent dans le substrat avec les matériaux de départ. Ils participent également, avec d’autres microorganismes, à la fermentation. Cet agent pathogène ne souffre pas à haute température. Dans ce cas, les micro-organismes restants meurent, le champignon adana commence à se développer encore plus rapidement, sans rencontrer d'obstacles ni de concurrents. Le mycélium de ce champignon est constitué de minces hyphes qui pénètrent dans l’ensemble du substrat et lui donnent l’odeur d’une cave et de moisissures. Le mycélium de Champignon ne peut pas se développer dans de telles conditions, car il ne trouve pas de nutriments. Il meurt très vite. Et le champignon parasite développe des spores. En conséquence, des boutons de couleur vert clair, vert olive et noir apparaissent sur le substrat. Le champignon porteur de spores est rempli de spores vertes. De plus, l'ammoniac dans le substrat et le manque d'air frais ne font que stimuler le développement de ce champignon. Si les excréments de poulet sont mélangés de manière inégale dans le mélange initial, cela provoque parfois l'apparition de moisissure verte.
A quoi ressemblent les champignons infectés par la moisissure verte, montrée sur la photo:

La moisissure verte ne peut être évitée. Pourquoi le matériau de départ pour les substrats devrait-il être pris uniquement avec le dosage approprié et correctement composté? Le processus de pasteurisation lui-même doit être surveillé en permanence, ne permettant en aucun cas une surchauffe.
Il est permis de secouer à nouveau le substrat affecté par la maladie. En conséquence, vous pouvez obtenir un faible rendement. Avant une telle manipulation, le substrat est généralement saupoudré de poudre de superphosphate.
Moisissure brune et jaune sur les pleurotes et les champignons

Moisissure brune affecte souvent les pleurotes et les champignons. Son agent causal est un champignon saprophyte moisi. De la moisissure peut apparaître sur le substrat avant ou après le remplissage du matériau de revêtement. Tout d'abord, la moisissure est blanche et duveteuse, puis elle devient brun-gris, sous forme de plaque. Si vous le tapotez sur la main ou si vous le versez, la poussière se soulève des taches. Lorsque le champignon mycélium germe dans le matériau tégumentaire, la moisissure du champignon disparaît.
Cette maladie ne peut qu'être prévenue, ses méthodes de traitement n'existent pas.À titre préventif, le matériau de couverture doit être traité avec du foundationazole. De plus, le compostage au sol n'en vaut pas la peine.

Moisissure jaune affecte également souvent les champignons. Elle est causée par un champignon parasite, Myceliophtora lutea; cet agent pathogène est l’un des plus dangereux pour les champignons. Un tel champignon peut être trouvé dans la nature - il parasite le mycélium sauvage de divers champignons. Et dans le substrat, il ne se développe que s'il y a aussi du mycélium champignon. Un mycélium blanchâtre apparaît à la limite entre le matériau de revêtement et le substrat. Après quoi les spores se forment et les zones touchées deviennent jaunes. Le substrat lui-même commence à sentir une odeur d'oxyde de cuivre ou de carbure. Les spores du champignon sont très résistantes aux températures élevées, elles ne meurent pas pendant la pasteurisation et peuvent être transportées avec la terre infectée par le substrat par les mains des personnes et des outils.
À des fins préventives, vous devez vous conformer strictement aux exigences sanitaires et au compost. Si le substrat est infecté, alors autour du champignon, toutes les semaines, il faut vaporiser une solution de formol à 4%. Et après chaque interruption, il est nécessaire de vaporiser une solution à 1% de sulfate de cuivre sur les épaules. Le substrat infecté est également traité avec une solution à 1% de sulfate de cuivre, puis acheminé vers une décharge. Ce substrat ne peut pas être utilisé comme engrais organique. Après chaque rotation des cultures, toutes les installations de production doivent être cuites à la vapeur pendant 12 heures à une température de 72 ° C.
Que faire si des moisissures de confettis apparaissent sur les champignons

Confettis de moisissure jaune Est une maladie différente de la moisissure jaune normale. Elle est causée par un autre type de champignon parasite. Un mycélium blanchâtre se forme dans le substrat sous forme de taches éparses. Ils jaunissent un peu plus tard et deviennent jaune-brun. Au milieu, des tissus fongiques peuvent même se former.
Développé simultanément avec le mycélium champignon, ce parasite commence à l'emporter progressivement. Les taches peuvent être clairement visibles à travers le sac. Ils sont même faciles à vérifier en versant le substrat du sac sur le papier et en le divisant en couches horizontales. La moisissure est généralement différente de celle du champignon mycélium, couleur - il est toujours gris argenté. En développement, l’effet déprimant de la maladie sur la fructification du champignon. Il ralentit d'abord, puis s'arrête finalement.
Le plus grand développement de moisissure se produit au 50-60ème jour après le semis du mycélium. Par conséquent, plus la fructification du champignon est tardive, plus les pertes seront importantes.
Les spores de ce champignon parasite moisi meurent à une température de 60 ° C et plus. Le plus souvent, la maladie se propage à travers le substrat, parfois elle peut aussi être trouvée sur le sol. L'infection peut pénétrer dans le substrat lorsqu'il est déchargé de la caméra. Les spores sont amenées par le vent avec la poussière des champignons voisins ou du substrat de déchets. Le sol peut aussi être infecté. Les litiges se déroulent avec des vêtements et des chaussures, des outils, des tiques, des souris, des mouches à champignons, etc.
Pour prévenir l'infection, il est nécessaire de respecter les exigences sanitaires à la fois dans le champignon lui-même et sur le territoire qui lui est adjacent. Le compostage ne doit pas être effectué sur un sol en terre. Le substrat doit être correctement pasteurisé pendant 12 heures à une température de 60 ° C. Il est préférable d’utiliser des sacs en film polymère, qui réduiront le risque de propagation de l’infection lors de la ponte des champignons. De plus, toutes les mesures doivent être rigoureusement effectuées (préparation d’un substrat de sélection, germination rapide du mycélium, mélange avec un substrat pasteurisé, etc.) qui accélèrent la croissance du mycélium et la formation de fruits. Cela contribuera à réduire le risque de perte de récolte.
Si les champignons sont encore recouverts de moisissure, les parures des cuisses et le revêtement qui y adhère ne peuvent pas être dispersés. Ils doivent être rassemblés dans des sacs de film polymère et placés dans un trou spécialement préparé à cet effet. Ces déchets doivent être arrosés chaque jour avec une solution de sulfate de cuivre. La fosse doit être recouverte de terre.La salle entière dans laquelle le champignon est emballé doit être lavée et désinfectée chaque jour avec une solution de sulfate de cuivre. Toutes les ouvertures de ventilation doivent être bloquées par des filets. Avant et après le travail au champignon, tous les outils de travail doivent être lavés, les vêtements de travail doivent être lavés, les chaussures doivent être lavées et assainies avec une solution de sulfate de cuivre, les mains doivent être lavées au savon.
Les principales mesures de lutte contre les moisissures sont préventives. Tout d'abord, il est nécessaire d'éliminer toutes les sources d'infection à tous les stades de la culture des champignons.
Pour que les moisissures n'apparaissent pas sur les champignons, il est nécessaire de pulvériser une fois par semaine tout le territoire du champignon avec une solution de sulfate de cuivre à 1%. Avant de le retirer du champignon, le substrat utilisé doit être traité avec une solution de sulfate de cuivre. Il ne peut être utilisé comme engrais organique que s'il n'y a pas de champignon. Les installations de production doivent également être traitées à la vapeur avec le substrat.
Moisissure jaune vert

Moisissure verte jaune le substrat dans les champignons est affecté assez souvent. Les champignons deviennent faibles, de couleur grise; le mycélium se meurt progressivement. À sa place, des champignons moisis se forment avec des spores jaune-vert et du mycélium blanchâtre. Il a une odeur caractéristique de moisissure et semble visqueux. Cette maladie est causée par plusieurs moisissures différentes. Ils sont capables de se développer en même temps et il est assez difficile de les isoler. Ce type de moisissure est commun dans la nature. Il entre dans le substrat avec les matériaux de départ et participe, avec d'autres micro-organismes, au compostage. La moisissure jaune-vert commence à se développer à une température de 45 ° C. Il meurt complètement avec une bonne pasteurisation. Si la pasteurisation est effectuée de mauvaise foi et que le substrat lui-même est de mauvaise qualité, la moisissure affecte rapidement le mycélium de Champignon aux premiers stades de développement. L'infection peut pénétrer dans un substrat de qualité. Les sources d'infection peuvent être un substrat de déchets infecté, qui est dispersé près du champignon et du compost, du vent et de la poussière, des chaussures, des outils. Il est trop tard pour réfléchir à ce qu’il faut faire quand les champignons sont déjà moisis. Si l'infection survient relativement tard, lorsque le mycélium est complètement formé et que la formation des fruits a commencé, le risque de perte de récolte est légèrement réduit.
Pour prévenir cette maladie, vous devez toujours respecter toutes les règles d'hygiène sur le site de compostage. N'utilisez pas de crottes d'oiseaux stockées depuis longtemps. Le compostage doit être effectué, en respectant toutes les exigences et en le plaçant au niveau des épaules. Le substrat doit toujours être traité thermiquement. De plus, il doit être humidifié immédiatement après en avoir extrait le champignon. Les jours de vent, il n'est pas souhaitable de le nettoyer. Le substrat épuisé doit être retiré dans des sacs en film plastique. Lavez les champignons régulièrement et désinfectez-les avec des fongicides.
Autres types de moisissures

Moule carmin causée par la moisissure Sporendomena purpurescens Bon. Il apparaît pendant la fructification sous forme de duvet blanc ou de couverture de mycélium entre des mottes tégumentales. Le mycélium de ce moule se développe très rapidement et recouvre toute la couche de matériau de revêtement. Il n'absorbe pas l'eau pendant l'irrigation. En champignon, la fructification diminue d'abord, puis cesse complètement. Le mycélium de moisissure tourne au jaune, devient ensuite rouge cerise et la formation de spores commence. Ce champignon aime beaucoup l'azote et se développe dans un substrat riche en celui-ci. Si la température du substrat atteint 10-18 ° C, la croissance des moisissures augmente, tandis que le développement des champignons cultivés ralentit.
Pour prévenir cette maladie, un substrat sursaturé en azote et gorgé d'eau doit être évité. Très soigneusement, les engrais azotés doivent être appliqués. Lors du traitement thermique du substrat, il doit certainement y avoir un afflux d'air frais. L'ammoniac doit être complètement libéré. La température du substrat doit également toujours être optimale pour le champignon cultivé.

Moisissure en toile d'araignée et olive - Les maladies les plus courantes des pleurotes. Ils apparaissent sur le substrat et inhibent la croissance du mycélium et la formation de fruits. Le sel est le moyen le plus simple et le plus efficace de lutter contre ces maladies. Il est généralement saupoudré de zones infectées. Le sel ne permet pas à la maladie de se propager davantage.







